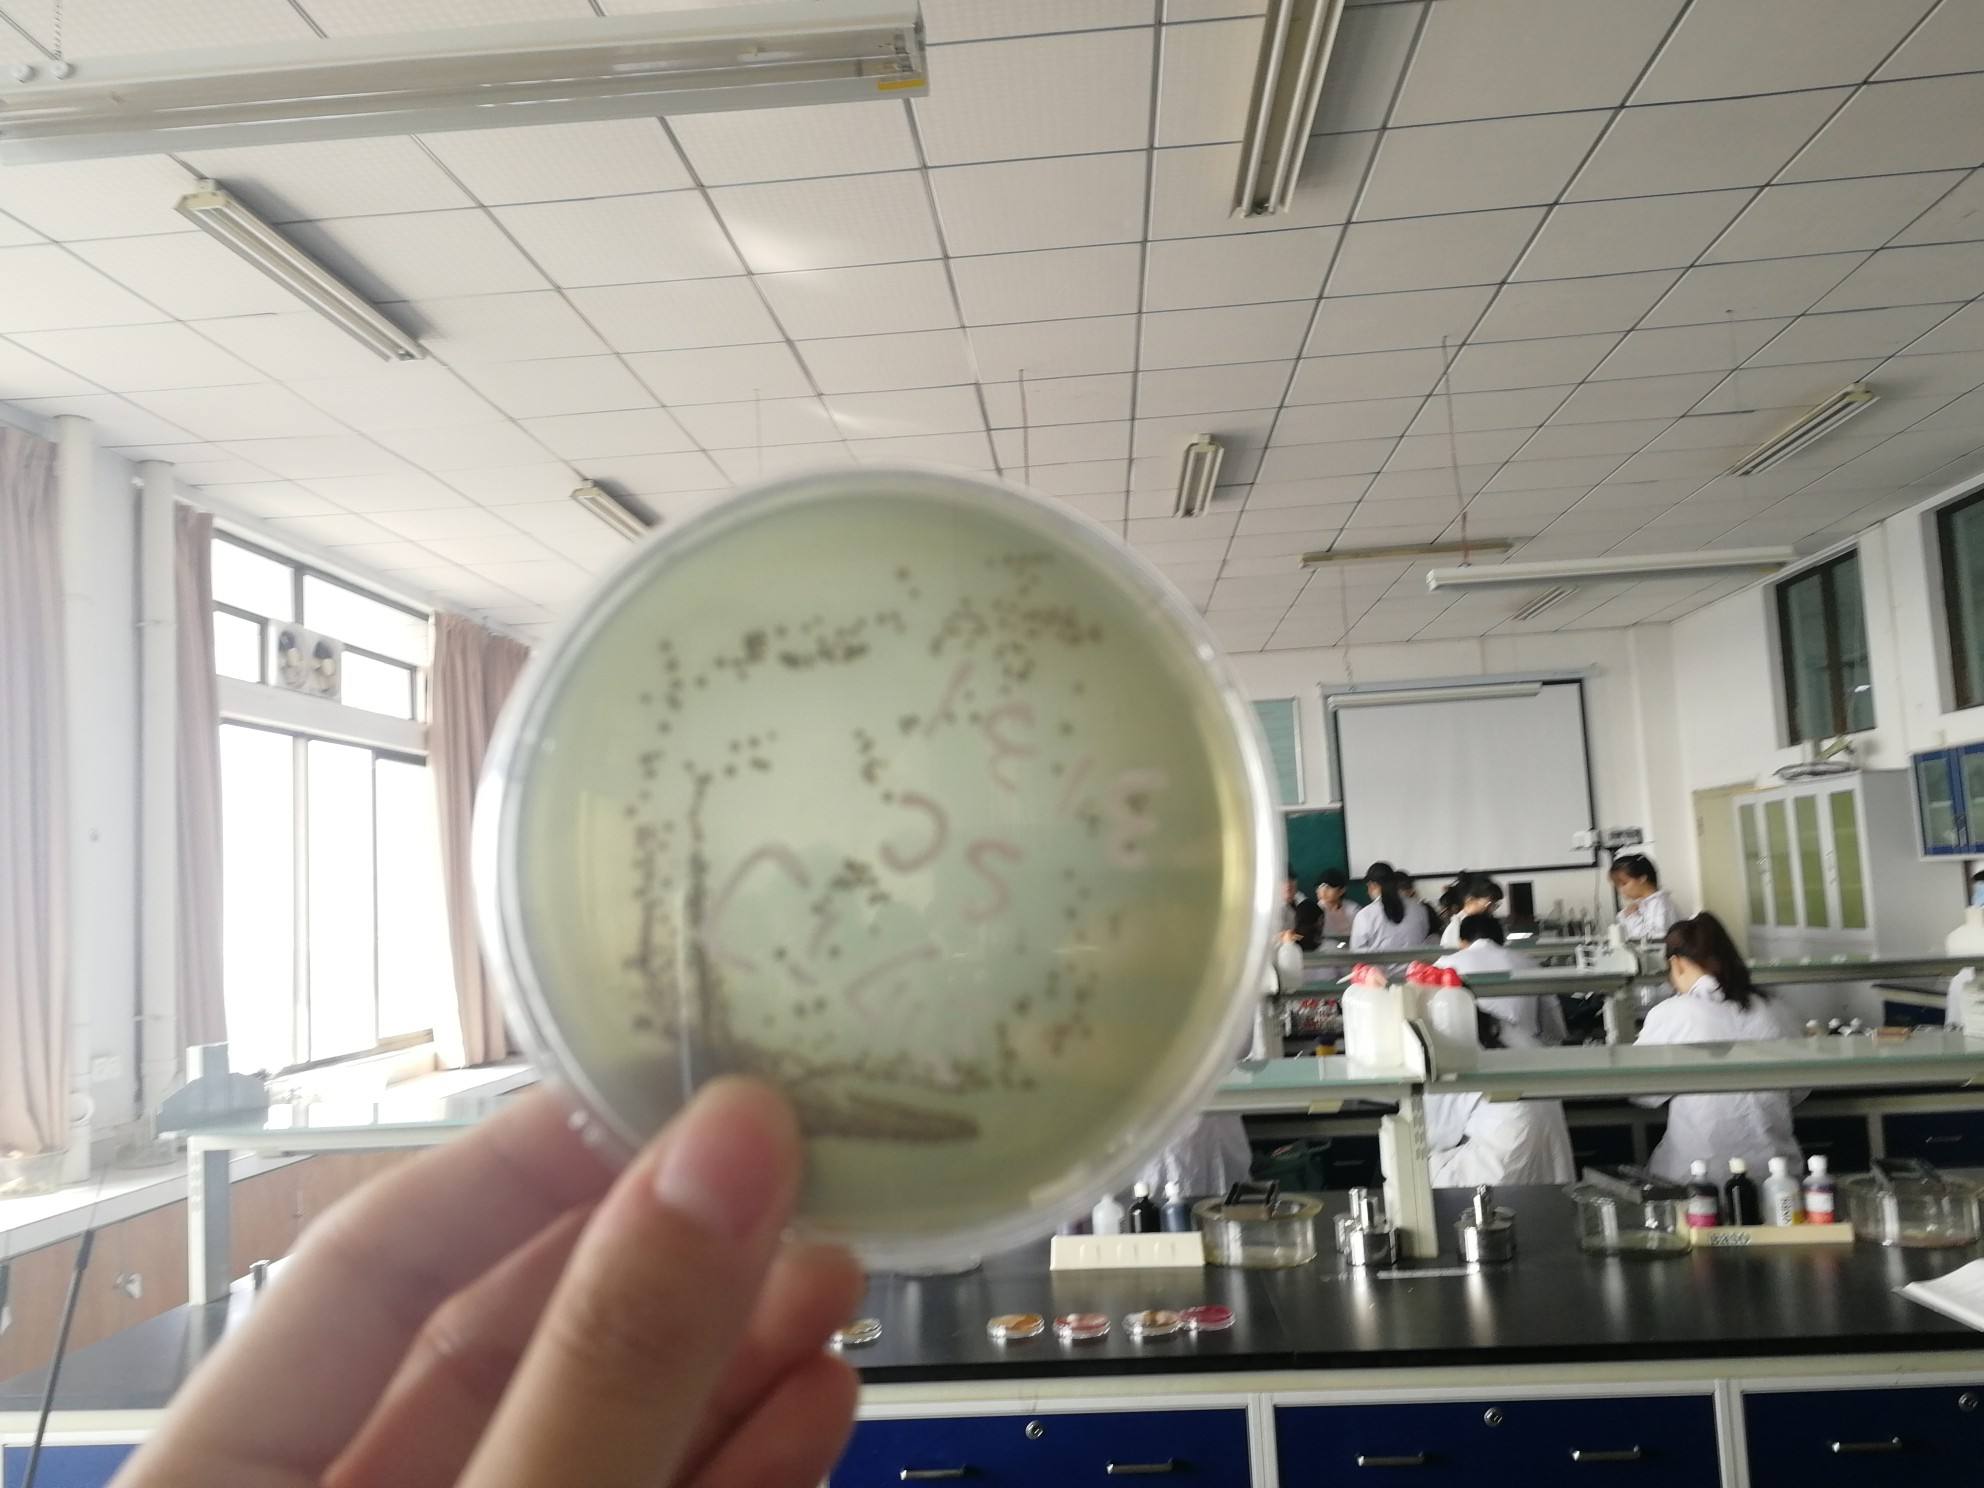
可生食鸡蛋的正确食用方法,达到可生食标准的鸡蛋可以生吃吗

“每天一颗鸡蛋,医生远离我”,众所周知,鸡蛋是“营养品”美味又健康,也是目前为止家家户户都会储存的食物,如今更是成为了自我国改革开放之后,市场发展最快的农业产品。

比如随着技术的发达,映入眼帘的以及近期十分火爆的还有“可生食的鸡蛋”。据说这样的鸡蛋,安全、健康、优质,不存在夹生的危险,那么真的安全吗?
鸡蛋的营养毋庸置疑:
现在,大家完全不用担心鸡蛋的营养,无论哪种品种整体营养价值都很高,在中国营养成分表中,可以看到每百克鸡蛋仅仅是蛋白质含量就能达到12.8g,且消化吸收利用率更是达98%以上。

即使是不被大家看好的鸡蛋黄,也有脂肪和胆固醇,但蛋黄里还有蛋白不能比拟的卵磷脂、维生素A、维生素B族、维生素D、钙、铁、磷,直接丢弃反而很可惜。
此外,之前关于吃鸡蛋会患心血管疾病的说法,已被辟谣。反而,涉及国内一项关于50多万人的研究发现,每天吃一个鸡蛋,对降低心脏病以及中风大有益处。

唯一需要大家注意的安全隐患,则是鸡蛋的吃法问题,那么关键点也来了,“可生食鸡蛋”究竟有没有问题呢?
主要分为两种情况:一种是普通生鸡蛋,估计很少有人亲自尝试过,最多也都是吃溏心蛋。这样的鸡蛋要和大家强调一下,由于溏心蛋烹饪的时间过短,蛋黄还没有彻底凝固属于流动的状态,很可能会存在“夹心”的现象。
在这种状态下,最应该注意的是沙门氏菌,它极易感染肉、蛋,轻则诱发肠胃疾病,重则还会影响生命甚至死亡。由此可见,不建议大家直接生吃普通的鸡蛋,或者吃大量的溏心蛋,安全性低。
另一种情况是符合我国可生食鸡蛋的标准,即国家级别动物健康以及食品安全联合发布创新联盟的《优质鸡蛋(可生食)标准》。

这样被誉为高端的鸡蛋,似然很吸引人,但针对我国人在无法保证食品安全的前提下,是不建议生吃鸡蛋,尤其是免疫力低下的人容易感染沙门氏菌。
对于喜欢吃寿喜锅的人群,在无法确定鸡蛋是否新鲜以及能直接作为蘸料食用的话,都应该避免,别拿身体健康当小事,到时候后悔可能就来不及了。